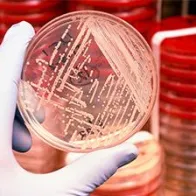
Antimicrobial resistance

Materials for professionals in hospitals and other healthcare settings
Materials for professionals in hospitals and other healthcare settings, such as long-term care facilities, who have different roles and influence in the use of antibiotics in such settings.